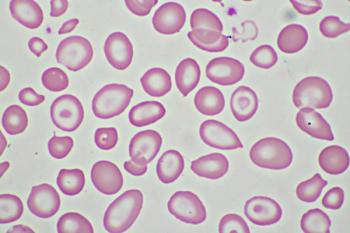

Experts discuss emerging agents in the pipeline for the treatment of RRMM; including BCMA-targeted bispecific antibodies.

Experts discuss emerging agents in the pipeline for the treatment of RRMM; including BCMA-targeted bispecific antibodies.

With numerous targets in CNS diseases and a unique partnership with gene therapy experts at UT Southwestern, Taysha is hoping to fill significant unmet needs.

A post-hoc analysis overviewed long-term efficacy of autologous hematopoietic stem cell transplantation in mantle cell lymphoma.

The hematologist from UC Health discussed the role of allogeneic stem cell transplant at first remission based on risk stratification.

The early-phase data readout follows news that the FDA recently approved its IND for its CAR-T candidate in multiple myeloma.

Experts discussed treatment for patients with transplant-ineligible diffuse large B-cell lymphoma.

The first US-based patient has been dosed in Lysogene’s clinical trial of LYS-GM101, following 2 other competing trials.

The associate professor from The University of Texas MD Anderson Cancer Center discussed future research with CAR T therapy in multiple myeloma.

Patients with MDS treated with alloHSCT and 5-aza had significant improvements in event-free survival compared to 5-aza treatment alone.

Experts discussed data from trials in lymphoma presented at ASCO 2021.

The chief of Oncology and Hematology at University of Nebraska Medical Center, discussed the potential utility of CAR T-cell therapy across the non-Hodgkin lymphoma (NHL) paradigm.

The 4-day virtual conference will feature plenary presentations, workshops, and bootcamps led by cell therapy industry leaders with expertise in discovery, development, manufacturing, and more.
Both Vertex and Arbor are adding to their list of gene and cell therapy partnerships with the announcement.

The chief executive and chief medical officers of Celyad Oncology discussed their platform and positive data presented at EHA 2021.

The 2 companies will focus their strategic partnership on the development of gene therapies for rare diseases, as well.

Mariya Moosajee, MBBS, BSc, PhD, FRCOphth, discussed the next generation of gene therapy for inherited retinal diseases.

The CAR T therapy tisagenlecleucel missed its EFS endpoint in the phase 3 BELINDA trial for B-cell non-Hodgkin lymphoma.

The research director at the Moran Eye Center discussed the genetics of developing age-related macular degeneration.

Presentations at ISTH 2021 revealed attributes most important to patients when considering gene therapies and where further research is needed.

The professor of medicine from Duke University School of Medicine discussed treatment approaches for after relapse on CAR T cell therapy or for patients who are ineligible for CAR T therapy.

Stephen M. Ansell, MD, PhD, discussed the potential of using non–CAR T-based novel approaches in the non-Hodgkin lymphoma treatment paradigm.

Salvador Rico, MD, PhD, chief medical officer, Encoded Therapeutics, discussed the different initiatives the company is conducting in Dravet syndrome.

FT516 and FT595 are both currently being evaluated in phase 1 trials for B-cell malignancies.

KITE-363 is set to be investigated in a phase 1 clinical trial at the end of 2021.

The 2-dose vaccine has been approved for use 9 months after its Emergency Use Authorization (EUA).

Edward Holland, MD, chief medical advisor, discussed an injectable technique where one cornea donor could potentially supply hundreds of patients with treatment for endothelial disease.

CAR T-cell therapy use will likely expand to a wider array of hematologic malignancies.

Nina Shah, MD, and other experts discuss the role of CAR T-cell therapy in relapsed/refractory multiple myeloma.

Iuliana Vaxman, MD, and Angela Dispenzieri, MD, review eligibility criteria for ASCT in AL amyloidosis, conditioning dosing, efficacy in terms of hematologic and organ response, and future areas of research.